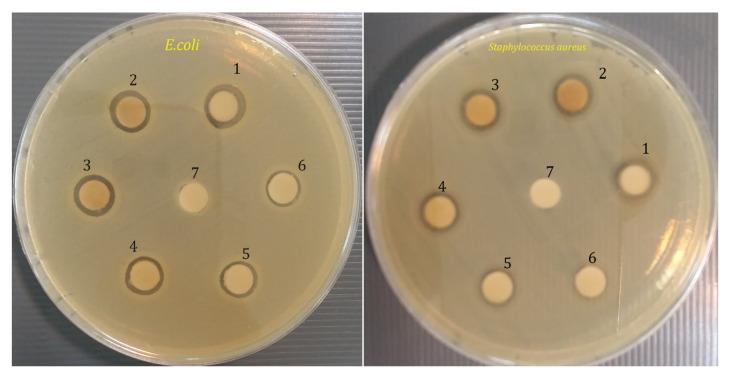
https://cdn.ncbi.nlm.nih.gov/pmc/blobs/da12/8537537/f6550f49d460/molecules-26-06140-g007.jpg

使用叶提取物绿色合成氧化锌纳米粒子:细胞毒性和抗菌性能的表征和体外评价。
Green Fabrication of Zinc Oxide Nanoparticles Using Leaf Extract: Characterization and In Vitro Evaluation of Cytotoxicity and Antibacterial Properties.
机构信息
Department of Biotechnology, College of Science, Taif University, P.O. Box 11099, Taif 21944, Saudi Arabia.
Department of Chemistry, College of Science, University of Misan, Maysan 62001, Iraq.
出版信息
Molecules. 2021 Oct 11;26(20):6140. doi: 10.3390/molecules26206140.
Green nanoparticle synthesis is an environmentally friendly approach that uses natural solvents. It is preferred over chemical and physical techniques due to the time and energy savings. This study aimed to synthesize zinc oxide nanoparticles (ZnO NPs) through a green method that used leaf extract as an effective reducing agent. The synthesis and characterization of ZnO NPs were confirmed by UV-Vis spectrophotometry, Fourier Transform Infrared Spectroscopy (FTIR), X-ray Diffraction (XRD), Dynamic light scattering (DLS), Zeta potential, and Field Emission Scanning Electron Microscope (FESEM) techniques. In vitro cytotoxicity was determined in L929 normal fibroblast cells using MTT assay. The antibacterial activity of ZnO nanoparticles was investigated using a disk-diffusion method against and , as well as minimum inhibitory concentration (MIC) and minimum bactericidal concentration (MBC) content concentrations. XRD results confirmed the nanoparticles' crystalline structure. Nanoparticle sizes were found to be around 79 nm by FESEM, whereas the hydrodynamic radius of nanoparticles was estimated to be around 165 ± 3 nm by DLS. FTIR spectra revealed the formation of ZnO bonding and surfactant molecule adsorption on the surface of ZnO NPs. It is interesting to observe that aqueous extracts of leave plant are efficient reducing agents for green synthesis of ZnO NPs in vitro, with no cytotoxic effect on L929 normal cells and a significant impact on the bacteria tested.
绿色纳米粒子合成是一种使用天然溶剂的环保方法。由于节省了时间和能源,它比化学和物理技术更受欢迎。本研究旨在通过一种绿色方法合成氧化锌纳米粒子 (ZnO NPs),该方法使用叶提取物作为有效的还原剂。通过紫外-可见分光光度法、傅里叶变换红外光谱 (FTIR)、X 射线衍射 (XRD)、动态光散射 (DLS)、Zeta 电位和场发射扫描电子显微镜 (FESEM) 技术确认了 ZnO NPs 的合成和表征。通过 MTT 测定法在 L929 正常成纤维细胞中测定体外细胞毒性。使用圆盘扩散法研究了 ZnO 纳米粒子对 和 的抗菌活性,以及最小抑菌浓度 (MIC) 和最小杀菌浓度 (MBC) 含量浓度。XRD 结果证实了纳米粒子的晶体结构。FESEM 发现纳米粒子的尺寸约为 79nm,而 DLS 估计纳米粒子的水动力半径约为 165±3nm。FTIR 光谱揭示了 ZnO 键的形成和表面活性剂分子在 ZnO NPs 上的吸附。有趣的是,观察到 叶植物的水提物是体外合成 ZnO NPs 的有效还原剂,对 L929 正常细胞没有细胞毒性作用,对测试的细菌有显著影响。